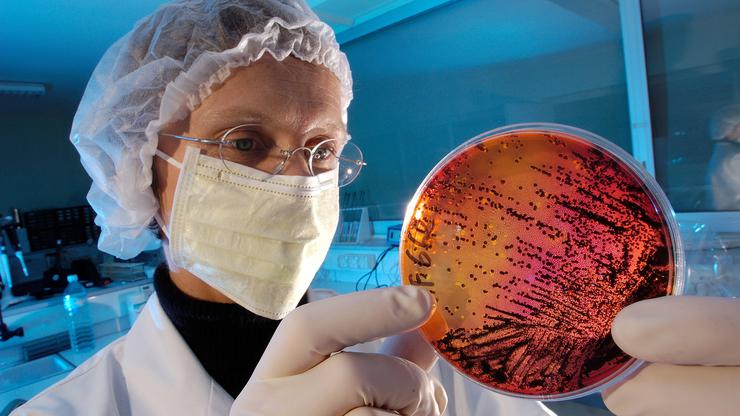

Superbakterije bi mogle uzrokovati smrt milijuna ljudi diljem svijeta i do 2050. globalno gospodarstvo godišnje koštati gotovo 2 bilijuna dolara, pokazuje modeliranje. Britanska vlada financirala je studiju koja pokazuje da bi , bez zajedničke akcije, porast stope antimikrobne otpornosti (AMR) mogao dovesti do godišnjih gubitaka globalnog BDP-a od 1,7 bilijuna dolara u sljedećih 25 godina. Istraživanje koje je proveo think-tank Center for Global Development pokazalo je da bi gospodarstva SAD-a, Ujedinjenog Kraljevstva i EU bila među najteže pogođenima, što je potaknulo kritike da su nedavni veliki rezovi u pomoći samodestruktivni, piše Guardian.
- Kada smo proveli istraživanje o ekonomskim utjecajima antimikrobne otpornosti, očekivalo se da će stope otpornosti nastaviti slijediti povijesne trendove. Međutim, nagli rezovi u službenoj razvojnoj pomoći, SAD su smanjile potrošnju za otprilike 80 posto, UK s 0,5 posto na 0,3 posto bruto nacionalnog dohotka, a znatna smanjenja uvele su i Francuska, Njemačka i druge, mogli bi povećati stope otpornosti prema najpesimističnijem scenariju našeg istraživanja - rekao je Anthony McDonnell, glavni autor i istraživač te politički savjetnik pri Center for Global Development. Istaknuo je opasnost od rezova a borbu protiv AMR-a.

- To bi dovelo do milijuna dodatnih smrti diljem svijeta, uključujući zemlje G7. Ulaganje u liječenje bakterijskih infekcija sada spašava živote i donosi milijarde u dugoročnim ekonomskim koristima - rekao je McDONNELL. Studija je izračunala ekonomski i zdravstveni teret antibiotske otpornosti za 122 zemlje i predvidjela da bi u najgorem scenariju do 2050. godišnji gubici BDP-a u Kini mogli iznositi gotovo 722 milijarde dolara, u SAD-u 295,7 milijardi, u EU 187 milijardi, Japanu 65,7 milijardi, a u Ujedinjenom Kraljevstvu 58,6 milijardi dolara, piše Guardian.
Prema Institute for Health Metrics and Evaluation (IHME), broj smrti uzrokovanih AMR-om do 2050. porast će za 60 posto, pri čemu se očekuje da će 1,34 milijuna ljudi godišnje u SAD-u i 184.000 u UK umirati zbog bakterija otpornih na antibiotike. Također se predviđa i značajan porast broja ozbiljno oboljelih zbog otpornih bakterija.
Superbakterije povećavaju broj hospitalizacija i produljuju trajanje i intenzitet bolničkog liječenja, zahtijevaju skuplje terapije druge linije i složeniju njegu, zbog čega su infekcije otporne na antibiotike otprilike dvostruko skuplje za liječenje u usporedbi s onima koje se lako liječe.
Studija procjenjuje da bi globalni zdravstveni troškovi liječenja AMR-a mogli porasti za gotovo 176 milijardi dolara godišnje, dok bi u UK narasli s 900 milijuna na 3,7 milijardi, a u SAD-u s 15,5 na gotovo 57 milijardi dolara. Povećane stope otpornosti također bi smanjile radnu snagu UK-a, EU-a i SAD-a za 0,8 posto, 0,6 posto i 0,4 posto prema istraživanju. Reagirajući na nalaze, dr. Mohsen Naghavi, profesor zdravstvene statistike pri IHME-u, rekao je:
- Danas prijetnja AMR-a raste, a bez hitne akcije svih dionika, lijekovi koje danas koristimo mogli bi prestati djelovati, što bi moglo učiniti i jednostavne infekcije smrtonosnima - izjavio je dr. Naghavi za Guardian.
To bi zahtijevalo političke promjene u SAD-u, Europi i UK-u, razvoj novih lijekova i povećanje svijesti javnosti o tome da antibiotici nisu učinkoviti protiv virusa, dodao je.
Glasnogovornik britanske vlade rekao je:
- Naš 10-godišnji zdravstveni plan prepoznaje antimikrobnu otpornost kao veliku prijetnju i obvezuje se na hitno suzbijanje njezina širenja, uključujući kroz razvoj novih cjepiva. Postigli smo značajan napredak – smanjili smo upotrebu antibiotika u mesnoj industriji i razvili prvi model pretplate u svijetu za poticanje razvoja novih tretmana. Također nastavljamo blisko surađivati s međunarodnim partnerima kako bismo ograničili globalno širenje AMR-a - rekao je glasnogovornik.